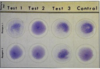

E. coli are Gram- _______ ____.
negative, rods
Are E.coli facultative or non-facultative anaerobes?
Facultative anerobes
E. coli are described as _______ flagella.
Peritrichous
E. coli ferments ______ and ______.
glucose, lactose
Is E. coli oxidase positive or negative?
Negative
Is E. coli catalase positive or negative?
positive
Where do E. coli normally live?
Normally live in the intestinal tract of all mammals (harmless)
Some cause serious infections when they escape the gut and invade other body sites or possess?
E. coli exhibit AMR towards which categories of medications?
β-lactams
Fluoroquinolones
What are the surface antigens of E.coli?
- LPS
- Somatic Antigen = O antigen
- Lipid A
- Fimbrial antigen (F)
- Capsular antigens (K)
- Flagellar Antigens (H)
Serotypes
E.coli O ____: H ____
E. coli O ____: K _____: H ____
157, 7
18,1,7
______ __ is the active component of _______ embedded in membrane. _____ antigen is a repeating PS extends from surface. O antigen is highly ______ region of bacteria.
Capsular = composed of _____ ______ - protein in nature
Fimbrae are _____ protein with _____ variation between strains.
Lipid A, endotoxin, LPS, variable, polysaccharides, Flagellar, surface, antigenic
What are the specific strains of E.coli that cause large bowel diarrhea?
Large bowel:
Enterohemorrhagic E. coli (EHEC)
Enteroinvasive E. coli (EIEC)*
- = human pathogen
What are the specific strains of E.coli that cause small bowel diarrhea?
Enterotoxigenic E. coli (ETEC)
Enteropathogenic E. coli (EPEC)
What are the fimbrial adhesions of Enteroteoxigenic E. coli (ETEC)? Where are they attached to?
F4, F5, F6, F41
Attachment to the small
intestine
Causes diarrhea (when you travel to another country).
What are the two enterotoxins that Enterotoxigenic E. coli possess?
Heat-labile enterotoxin (LT) –> cAMP
Heat-stable enterotoxin (ST) –> cGMP
Regulate absoprtion and secretion in villus epithelial cells. Pump out etaer nad bicarb while inhibitng fluid absorption from intestine. –> Lt and ST produced. Imbalance in ion and cell excretes water –> water diarrhea
Enterotoxigenic E. coli causes ?
Watery diarrhea

Which animals serve as hosts of Enteric colibacillosis - Neonatal diarrhea? At what age are these hosts affected?
Newborn calves, lambs, and piglets.
Within their first week of life (host-specific). why? Neonates have fimibrial recpetors in intestinal lining. As age increases, recptors shed and become less susceptible to ETEC.
What are the symptoms of Enteric colibacillosis - Neonatal diarrhea?
Diarrhea
Severe dehydration
Death
How do you treat a patient diagnosed with Enteric Colibacillosis - Neonatal diarrhea?
Milk with fluids containing electrolytes can prevent dehydration.
How do you control the spread of Enteric Colibacillosis- Neonatal diarrhea?
Antibiotics are not typically prescribed. Feeding ample amounts of colostrum shortly after birth.
What pathogen causes Enteric Colibacillosis - Neonatal diarrhea?
ETEC
Which animals serve as hosts of Enteric colibacillosis - Post-weaning diarrhea? At what age are these hosts affected?
Pigs within 1 to 2 weeks after weaning
What pathogen causes Enteric Colibacillosis - Post-weaning diarrhea?
ETEC (or EPEC)